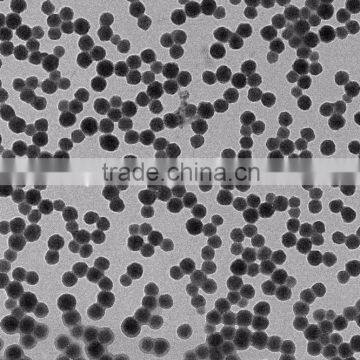
Acidic Colloidal Silica Sol for Polishing photo-5

Acidic Colloidal Silica Sol for Polishing
Industry :
Coating Textile Casting Ceramics Papermaking Battery Catalyst Polishing Painting Chemical. |
|
||
 |
|
Product details
SiO2,%: 25-30
Na2O,%≤: 0.05
PH value: 2.0-4.0
Viscosity (25), mp a.s ≤: 3.5-7
Density (25), g/cm3: 1.15-1.20
Particle Size,nm: 10-20 |
|
|
||
|
We have sample partner like Sinopec, WISCO, SinoSteel, MCC, ASD, Golden Ring , PetroChina and etc. We used to have offer high quality products for them. We looking forwarder to make business with you.
|
|
|
Our client :Grace From US Grace is one of our clients. We have so many cooperation in different industies.
|
| Our Sales Team JinWei group have more than 30 sales. We believed excellent service is the most important in bussiness.
|

|


|
FAQ. Frequently Asked Questions |
|
|
| ||

Send Inquiry to This Supplier
You May Also Like
-
High Efficiency Mould Release Agent Silicone Type for Rubber & Composite PartsUS$ 2 - 5MOQ: 1000 Kilograms
-
Cyanuric Acid 25kgNegotiableMOQ: 1 Ton
-
Zeolite Carbon Sieves 3a 4a 13x Adsorbent for Oxygen Concentrator Generator Molecular SieveNegotiableMOQ: 1
-
Modified Starch for Paper IndustrialUS$ 630 - 650MOQ: 5 Tons
-
NA Cmc Powder Food GradeUS$ 550 - 3,690MOQ: 5 Tons
-
Diapers Baler Hydraulic Pressing Baling MachineUS$ 3,200 - 3,250MOQ: 1 Set
-
Leather Wall Panel for Background and Ceiling PanelUS$ 3 - 6MOQ: 200 Pieces
-
AC Blowing Foam Blowing Agents of AzodicarbonamideUS$ 2,100 - 2,680MOQ: 1 Ton
-
High Quality Anionic Polyacrylamide Water Treatment Chemicals Polymer /PAM for Waste Water/Oil Drilling/MiningUS$ 1,000 - 2,600MOQ: 1 Metric Ton
-
10-0132 T/r/l Suiting FabricUS$ 2 - 3MOQ: 3000 Meters